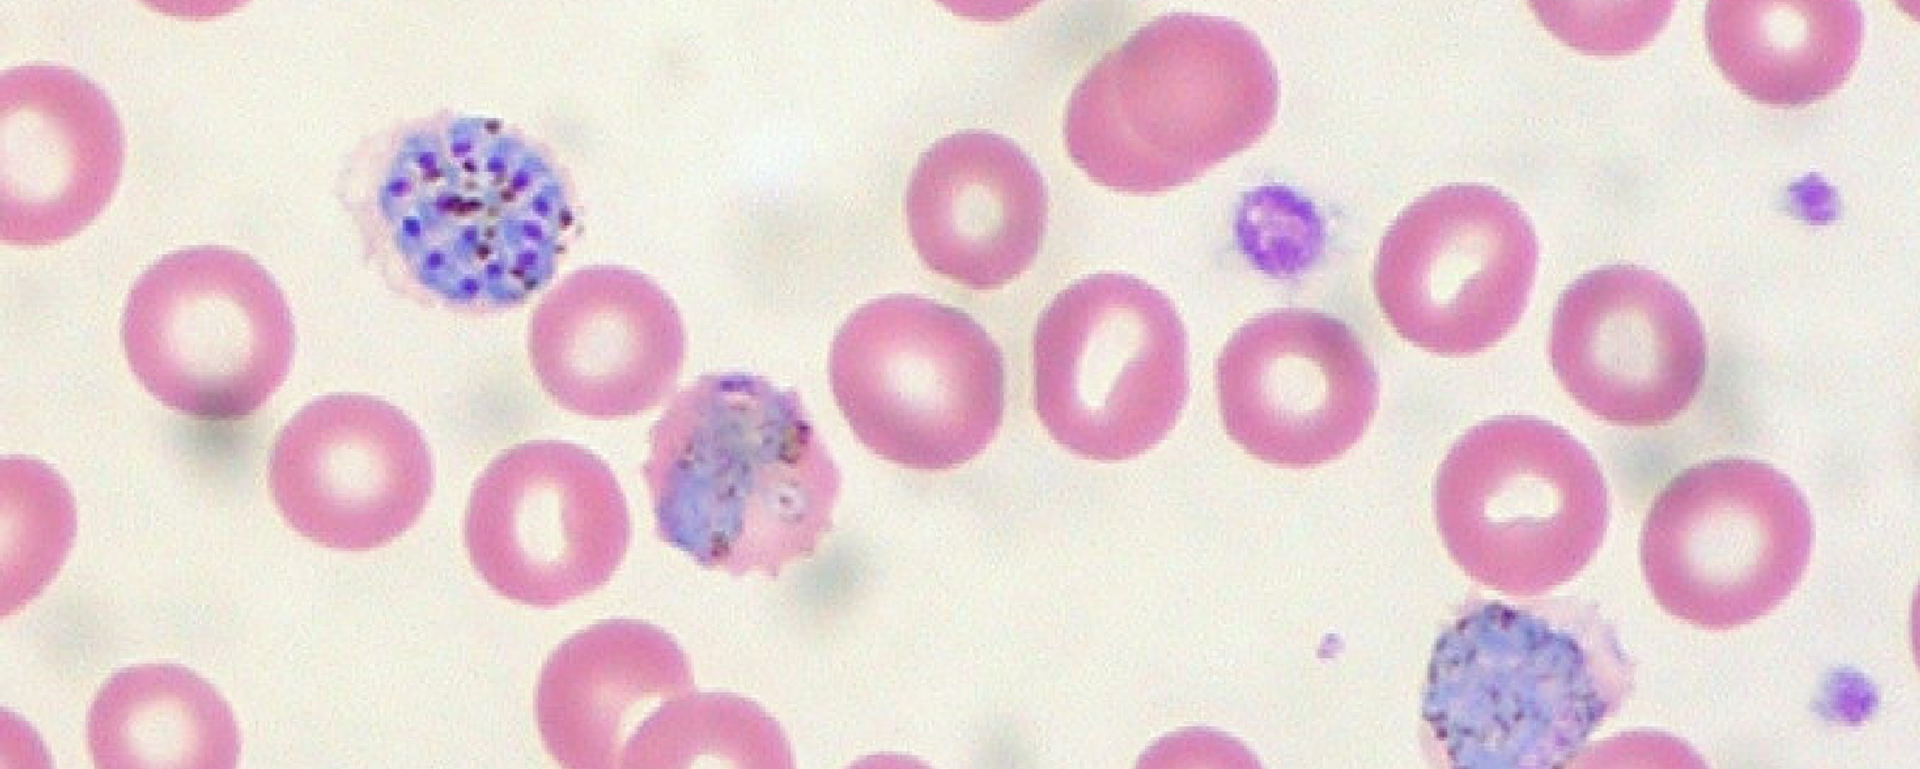
Muestra de sangre - Sputnik Mundo, 1920, 26.04.2021

https://noticiaslatam.lat/20210708/estiman-que-unos-8400-millones-de-personas-contraerian-dengue-y-malaria-antes-de-2100-1113929058.html
Estiman que unos 8.400 millones de personas contraerían dengue y malaria antes de 2100
Estiman que unos 8.400 millones de personas contraerían dengue y malaria antes de 2100
Sputnik Mundo
LONDRES (Sputnik) — Los científicos de la Escuela de Higiene y Medicina Tropical del Reino Unido revelaron que, si las emisiones de gases de efecto invernadero... 08.07.2021, Sputnik Mundo
2021-07-08T16:55+0000
2021-07-08T16:55+0000
2021-07-08T16:55+0000
💗 salud
dengue
malaria
cambio climático
https://cdn.img.noticiaslatam.lat/img/107778/57/1077785787_0:0:3033:1707_1920x0_80_0_0_d9552e97b84fffd6c584ecf1bc9a42c0.jpg
El centro científico afirmó que la población que está en riesgo de contraer malaria y dengue, en "el peor de los casos", puede crecer en 4.700 millones en comparación con el período comprendido entre 1970 y 1999. Este escenario es posible si para el año 2100 la temperatura en el planeta sube 3,7 grados centígrados.Los más amenazados serían los habitantes de las zonas que se encuentran a poca altura con respecto al nivel del mar y de las áreas urbanas.Los científicos subrayaron que el cambio climático amenaza con aumentar la duración de la temporada en que se propagan los virus.El estudio, dirigido por la Escuela de Higiene y Medicina Tropical de Londres contó con la participación de estudiosos de la Universidad de Umea (Suecia), del Centro Internacional Abdus Salam de Física Teórica (Italia), Universidad de Heidelberg (Alemania), y la Universidad de Liverpool.Los resultados de la investigación se publicaron en la revista The Lancet Planetary Health.
https://noticiaslatam.lat/20210426/1111587188.html
Sputnik Mundo
contacto@sputniknews.com
+74956456601
MIA „Rossiya Segodnya“
2021
Sputnik Mundo
contacto@sputniknews.com
+74956456601
MIA „Rossiya Segodnya“
Noticias
es_ES
Sputnik Mundo
contacto@sputniknews.com
+74956456601
MIA „Rossiya Segodnya“
https://cdn.img.noticiaslatam.lat/img/107778/57/1077785787_0:0:2677:2008_1920x0_80_0_0_bd7ee1038aa98507ab1572687a0e50b9.jpgSputnik Mundo
contacto@sputniknews.com
+74956456601
MIA „Rossiya Segodnya“
💗 salud, dengue, malaria, cambio climático
💗 salud, dengue, malaria, cambio climático
Estiman que unos 8.400 millones de personas contraerían dengue y malaria antes de 2100
LONDRES (Sputnik) — Los científicos de la Escuela de Higiene y Medicina Tropical del Reino Unido revelaron que, si las emisiones de gases de efecto invernadero continúan creciendo al ritmo actual, para fines de este siglo alrededor de 8.400 millones de personas podrían contagiarse de malaria y dengue.
"Si las emisiones continúan aumentando al ritmo actual, para fines de siglo aproximadamente 8.400 millones de personas podrían estar en riesgo de contraer malaria y dengue", señala el sitio web del centro de investigaciones.
El centro científico afirmó que la población que está en riesgo de contraer
malaria y
dengue, en "el peor de los casos", puede crecer en 4.700 millones en comparación con el período comprendido entre 1970 y 1999. Este escenario es posible si para el año 2100 la temperatura en el planeta sube
3,7 grados centígrados.
Los más amenazados serían los habitantes de las zonas que se encuentran a poca altura con respecto al nivel del mar y de las áreas urbanas.
Los científicos subrayaron que el cambio climático amenaza con aumentar la duración de la temporada en que se propagan los virus.
26 de abril 2021, 18:15 GMT
"Reducir las emisiones de gases de efecto invernadero puede prevenir que millones de personas contraigan la malaria y el dengue", señaló uno de los autores del estudio, el profesor asistente Felipe Colón González.
El estudio, dirigido por la Escuela de Higiene y Medicina Tropical de Londres contó con la participación de estudiosos de la Universidad de Umea (Suecia), del Centro Internacional Abdus Salam de Física Teórica (Italia), Universidad de Heidelberg (Alemania), y la Universidad de Liverpool.
Los resultados de la investigación se publicaron en la revista The Lancet Planetary Health.